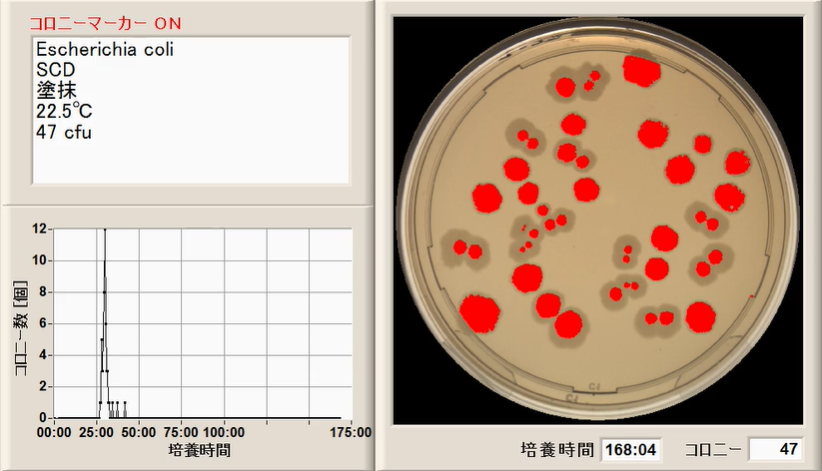
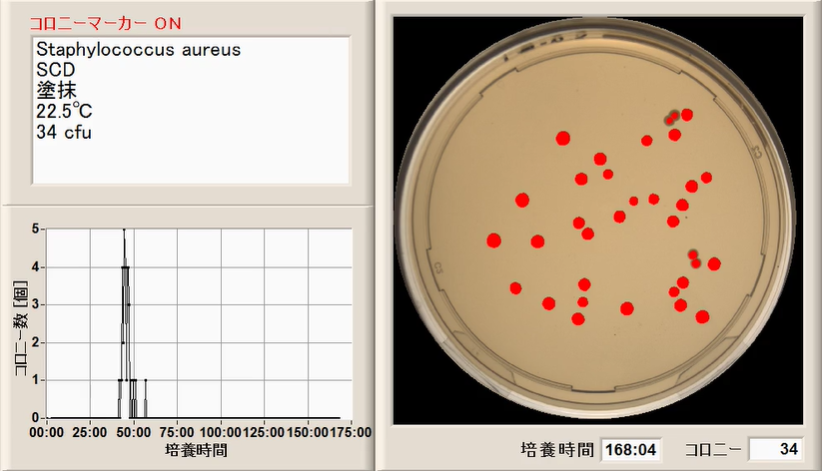
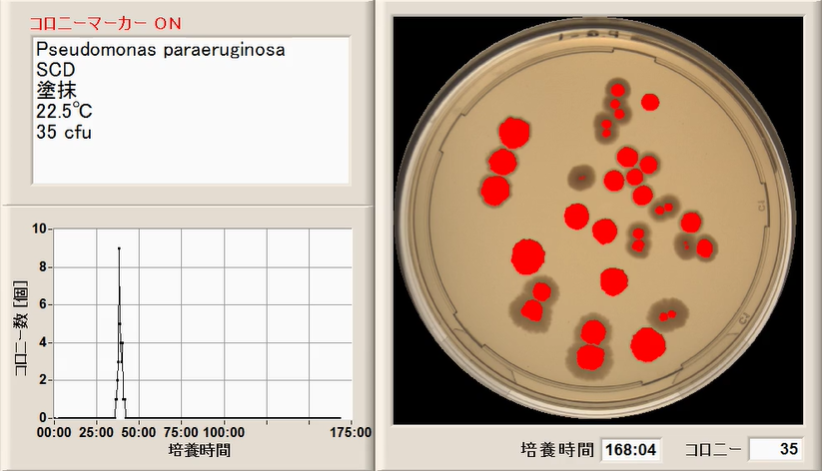
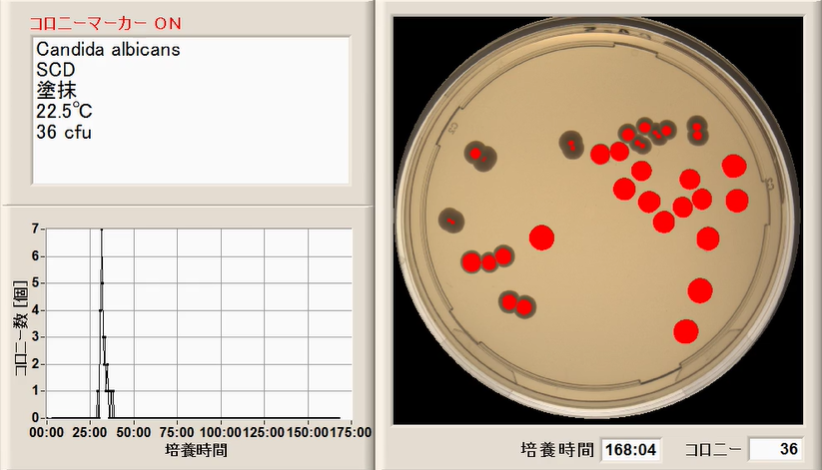
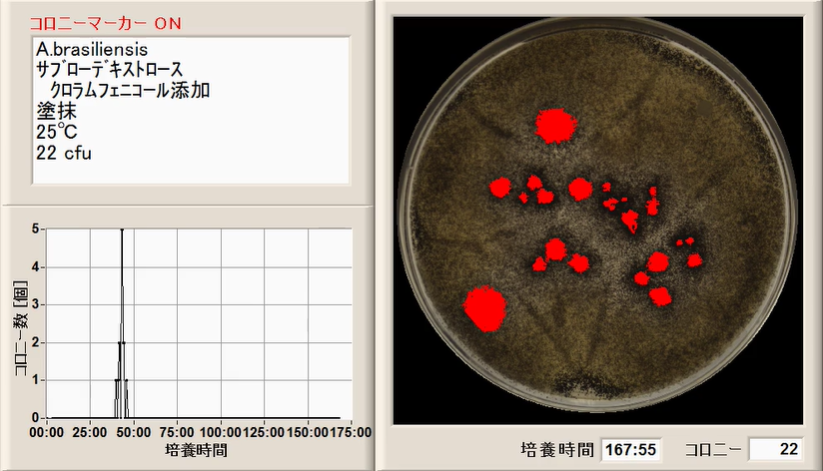

チャレンジテスト(保存効力試験)
日本薬局方(JP)が規定している保存効力試験は、化粧品などの試料に含まれる防腐剤の効力を、試験菌液を一定量(菌数)を寒天培地に接種して、試料を培養しながら、長期間(例えば、7日間)に渡り、微生物によるコロニーの出現を観察して、コロニーの増減を確認し、保存効力を確認する作業になります。
これは、人手による目視検査で実施するには、労力の要するたいへんな作業であるためか、チャレンジテストと呼ばれています。
AutoScanner を採用すれば、
(Compac 25でもできます.)
保存 と 生菌数計数 の
全ての工程が 全自動 になります。
※参考資料 日本防菌防黴学会第52回年次大会
シンポジウム 「防腐力試験の迅速化の提案」
防腐力設定
1.チャレンジテストの前に、防腐力を次の菌を使用して設定します。
・大腸菌: Escherichia coli ( NBRC 3972) 通性嫌気性菌 グラム陰性菌
・黄色ブドウ球菌:Staphylococcus aureus (NBRC 13276) 通性嫌気性菌 グラム陽性菌
・カンジダ菌: Candida albicans (NBRC 1594) 通性嫌気性菌 真菌
・アクネ菌: Cutibacterium acne 通性嫌気性菌 グラム陽性菌
※この菌は、増殖に対する影響を確認したいときに実施します。
2.検査キット(SensiMedia)を用いて、 迅速に防腐力を確認します。
![]() SM017 ( SCDLP )
SM017 ( SCDLP )
(1) センシメディア SM017 (SCDLP) のキャップを開けて、試料(化粧品)を 1ml(1g)を混合します。
これを5本用意します。
(2) 各試験菌の希釈系列の菌液を10の6乗程度から5段階調製します。

(3) 試料検体への試験菌液の接種
・試料入り検体:5本の検体入り検査キットに、それぞれの希釈系列の菌液1mlずつ添加します。
・コントロール: 5本のセンシメディアに、それぞれの希釈系列の菌液1mlずつ添加します。
(4) 5本の検体とコントロール5本を所定温度(20~25℃)で、48時間培養します。
(5)3菌種(細菌、真菌)で、48時間で防腐力が確認できます。
基本的に防腐剤は殺菌剤ということですので、菌の細胞壁の造り(グラム陰性か、グラム陽性か、)が大きく関係してきます。防腐剤の適切な濃度設定は、比較的容易にできます。防腐力の "見えるか" ができています。


保存効力試験(チャレンジテスト)
試験手順
*日本薬局方(JP)に基づいた方法
(1) 試験菌液の調製
試験菌を培養して食塩水などに懸濁し、試験菌液を調製します。
(2) 検体への試験菌液の接種
検体に試験菌液を一定量(菌数)接種します。
(3) 検体をAutoScannerに装填します。
(保存と生菌数計数が自動的に実施されます。)
・保存 (遮光下、22.5±2.5℃で保存します(例:7日)。)
・生菌数計数
評価
ヒストグラムと画像で試験菌の減少・増加度合いを確認し、
保存効力を評価します。
大腸菌(Escherichia coli) NBRC 3972
黄色ブドウ球菌(Staphylococcus aureus) NBRC 13276
緑膿菌(Pseudomonas aeruginosa) NBRC 13275
カンジダ菌(Candida albicans) NBRC 1594
クロコウジカビ(Aspergillus brasiliensis) NBRC 9455
Note)
ヒストグラム(histogram)、スペクトラム(spectrum) については、
AutoScannerの説明(p.12~)を参照してください。
 ※サブスク「らくらく導入パック」もあります。
※サブスク「らくらく導入パック」もあります。
 ※サブスク{らくらく導入パック」もありますが、月極レンタルもあります。
※サブスク{らくらく導入パック」もありますが、月極レンタルもあります。
デモ試験できます。(全国どこでも)
お問合せは、お気軽に どうそ
※お問い合わせ担当は、当社代表になります。
![マイクロバイオ株式会社 [微生物検査の全自動化・迅速化の提供]](./img/logo.png)